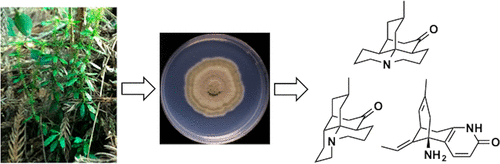
Lycopodium

Pharmacognosy
Staffs
Toshiaki Makino, Ph.D., Professor
Kan'ichiro Ishiuchi, Ph.D., Associate Professor
Kazuyoshi Terasaka, Ph.D., Assistant Professor
Kan'ichiro Ishiuchi, Ph.D., Associate Professor
Kazuyoshi Terasaka, Ph.D., Assistant Professor
Research Project
- Clinical and Experimental Pharmacology of Kampo Medicines
- Molecular & Cellular Biology of Plant Secondary Metabolism
- Natural Product Chemistry using Endogenous Bacteria
- Quality Control for Natural Medicaments
Utility of Kampo medicine (Japanese traditional medicine) or traditional Chinese medicine (TCM) rises more and more to treat the life-style related diseases, chronic disease or a physical phenotypic disorder that are hard to be cured in contemporary medicine. However, we cannot but say that the scientific evidences (EBM) are still insufficient. We are studying the evidences of kampo or TCM using experimental animal models for chronic disease, allergic diseases and stress disorders using pharmacological, pharmacolinetic and pharmacodynamic approaches. Furthermore, we are supplying the drug information of kampo and TCM such as drug interaction with Western medicine, or pharmacokinetics of the composition of kampo or TCM.
The origins of the most of crude drugs are plants, and their active ingredients are the secondary metabolites. It is assumed that the secondary metabolites which plants produce are beyond 50,000 kinds, and the chemical constitution is extremely complicated and has various bioactivity. We are also performing studyies that aimed at the productive efficiency of plant secondary metabolites and new bioactive compounds by evaluating biosynthesis, enzymatic isolation and functional analysis using various plant culture cells, and by analyzing the characteristics of those biosynthetic enzymes in molecular level.
The origins of the most of crude drugs are plants, and their active ingredients are the secondary metabolites. It is assumed that the secondary metabolites which plants produce are beyond 50,000 kinds, and the chemical constitution is extremely complicated and has various bioactivity. We are also performing studyies that aimed at the productive efficiency of plant secondary metabolites and new bioactive compounds by evaluating biosynthesis, enzymatic isolation and functional analysis using various plant culture cells, and by analyzing the characteristics of those biosynthetic enzymes in molecular level.








Contact Information
Graduate School of Pharmaceutical Sciences, Nagoya City University,
3-1, Tanabe-dori, Mizuho-ku, Nagoya 467-8603, Japan
E-mail:makino@phar.nagoya-cu.ac.jp
TEL/FAX:+81-52-836-3416
3-1, Tanabe-dori, Mizuho-ku, Nagoya 467-8603, Japan
E-mail:makino@phar.nagoya-cu.ac.jp
TEL/FAX:+81-52-836-3416